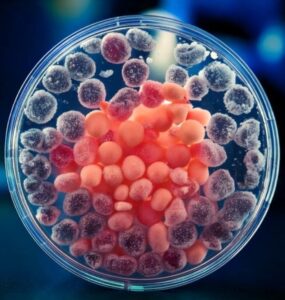

ADHD Stem Cell Treatment: Understanding Emerging Neurodevelopmental Pathways
Key Takeaways: Navigating ADHD and Advanced Care
- **ADHD is a complex neurodevelopmental condition:** Characterized by challenges in attention, hyperactivity, and impulsivity, often linked to dopaminergic regulation and brain network function.
- **Conventional approaches are foundational:** Standard care often involves medication, behavioral therapy, and lifestyle adjustments, as outlined by global health authorities.
- **Regenerative medicine is an evolving field:** Stem cell research for neurodevelopmental disorders like ADHD is in early stages, exploring potential mechanisms but not yet offering proven therapies.
- **Pereira, Colombia offers unique advantages:** Beyond clinical considerations, its advanced medical infrastructure and supportive environment provide a compelling setting for ethically exploring complex medical pathways.
- **Informed decision-making is paramount:** Our approach emphasizes education, transparent evaluation, and patient advocacy to help you understand the current science and determine suitability for advanced options.
Table of Contents
- Introduction: Exploring the Horizon of ADHD Care
- The Stakes & Critical Implications of Attention Deficit Hyperactivity Disorder (ADHD)
- The Conventional Approach to ADHD Management
- The Pereira, Colombia Advantage: A Context for Advanced Exploration
- The Clarity Compass for ADHD Treatment Pathways: Your Informed Choice Checklist
- Our Regenerative Philosophy & Approach for Neurodevelopmental Care
- Overcoming Common Hesitations: Why Seeking Clarity is a Strategic Advantage
- Glossary of Key Terms
- Frequently Asked Questions (FAQs)
- Next Steps: Your Confidential Case Review
Introduction: Exploring the Horizon of ADHD Care
Living with Attention Deficit Hyperactivity Disorder (ADHD) often means navigating a landscape of challenges—from focus and organization to emotional regulation. The journey can be arduous, and for many, the search for effective, lasting solutions is ongoing. You’ve likely explored many avenues, perhaps feeling the weight of the condition’s impact and the hope for something more. This pursuit naturally leads to investigating emerging fields like regenerative medicine, particularly the potential role of stem cell research in addressing the underlying neurodevelopmental aspects of ADHD.
It’s important to approach this topic with both curiosity and a critical eye. At Regencord in Pereira, Colombia, our team understands that patients navigating advanced care for conditions like ADHD often grapple with distinguishing between genuine scientific progress and unverified claims. Our experience underscores that clear, ethical education, precisely tailored to their individual journey, is paramount for empowering truly informed decisions. This comprehensive guide aims to illuminate the current understanding of ADHD, the evolving landscape of stem cell research, and how a destination like Pereira, Colombia, offers a unique context for exploring these advanced pathways.
The Stakes & Critical Implications of Attention Deficit Hyperactivity Disorder (ADHD)
ADHD is a neurodevelopmental disorder affecting millions worldwide, impacting children and adults across various aspects of life, including academic performance, professional careers, and personal relationships. It’s characterized by persistent patterns of inattention, hyperactivity, and impulsivity that interfere with daily functioning and development.
Understanding the Neurobiological Basis of ADHD
The complexity of ADHD stems from its neurobiological underpinnings. Research, often highlighted by institutions like the U.S. National Institutes of Health (NIH) and numerous PubMed-indexed peer-reviewed journals, points to differences in brain structure and function in individuals with ADHD. Key areas of focus include:
- **Dopaminergic Regulation:** Dopamine, a neurotransmitter, plays a crucial role in regulating attention, motivation, and reward. Imbalances in dopaminergic regulation are a well-researched component of ADHD, influencing the brain’s ability to focus and inhibit impulsive behaviors.
- **Brain Networks:** Studies indicate alterations in several brain networks, particularly those involved in executive functions such as planning, working memory, and self-control. This neurodevelopmental aspect means that the condition arises from how the brain develops and processes information.
- **Genetic and Environmental Factors:** While the exact cause remains multifaceted, a strong genetic component is recognized, alongside the influence of certain environmental factors.
The World Health Organization (WHO) acknowledges ADHD as a significant public health concern, underscoring the need for effective strategies to manage its symptoms and improve quality of life for affected individuals.
The Conventional Approach to ADHD Management

For decades, conventional treatment strategies for ADHD have focused on managing symptoms to improve daily functioning. These approaches are well-established and form the first line of defense for most individuals.
Pillars of Standard ADHD Care
In many healthcare systems, including those guided by the Colombian Ministry of Health and international guidelines, the conventional approach typically involves a combination of:
- **Medication:** Stimulant and non-stimulant medications are often prescribed to help regulate neurotransmitters like dopamine, aiming to improve focus and reduce hyperactivity and impulsivity.
- **Behavioral Therapy:** This includes strategies to teach coping mechanisms, organizational skills, and impulse control. For children, parent training and school-based interventions are vital.
- **Lifestyle Adjustments:** Regular exercise, a balanced diet, sufficient sleep, and mindfulness practices can complement other treatments and contribute to overall well-being.
While these conventional methods are often effective for many, some individuals continue to seek additional avenues, leading to the exploration of emerging fields like regenerative medicine.
The Pereira, Colombia Advantage: A Context for Advanced Exploration

As patients consider advanced pathways for neurodevelopmental conditions, the destination for care becomes as important as the clinical approach. Pereira, Colombia, offers a unique confluence of factors that make it a compelling location for exploring complex medical options.
Robust Healthcare Infrastructure and Standards
Colombia has invested significantly in its healthcare system, boasting modern medical facilities and a highly trained medical community. Regulatory bodies such as the Colombian Ministry of Health and INVIMA (National Food and Drug Surveillance Institute) uphold national standards for medical practice and ensure oversight of health-related products and procedures. This regulatory environment provides a framework of safety and legitimacy for advanced medical considerations.
A Supportive and Serene Environment
Beyond the clinic, the broader patient environment plays a pivotal role in recovery and well-being. Pereira, nestled in the heart of Colombia’s coffee region, offers a distinct advantage with its unique blend of advanced medical infrastructure and serene, supportive natural surroundings. This fosters a focused and less stressful experience crucial for those exploring complex medical pathways. The city’s welcoming culture and focus on patient-centered care contribute to a more holistic journey, contrasting with the often clinical and rushed environments found elsewhere.
Dedicated Patient Advocacy
For those considering medical travel, navigating a foreign healthcare system can seem overwhelming. The team at Regencord in Pereira, Colombia, understands this profoundly. Our patient advocacy approach is designed to simplify every step, offering clear communication, logistical support, and a compassionate presence. We aim to transform a potentially daunting journey into a well-supported, focused experience, allowing you to prioritize your health and evaluation process.
The Clarity Compass for ADHD Treatment Pathways: Your Informed Choice Checklist
Navigating the complex world of ADHD and advanced regenerative options requires a clear roadmap. To empower your decision-making, we’ve developed “The Clarity Compass for ADHD Treatment Pathways” – a structured guide to help you ask the right questions and evaluate information effectively.
How to Use The Clarity Compass:
- **Understand Your Current Condition:**
- Have I received a formal diagnosis of ADHD from a qualified medical professional?
- What conventional treatments have I tried, and what were their outcomes?
- What are my primary symptoms and challenges currently?
- **Research the Science (Source Verification):**
- Am I seeking information from reputable sources (e.g., NIH, PubMed-indexed journals, WHO, established medical institutions)?
- Do I understand the difference between preclinical research, clinical trials, and approved therapies?
- Are claims of effectiveness for stem cell treatments for ADHD backed by robust, peer-reviewed evidence?
- **Evaluate Potential Pathways:**
- Am I considering options that emphasize patient safety and ethical guidelines?
- Is the process for patient suitability evaluation transparent and comprehensive?
- Are the potential benefits and limitations of any advanced pathway clearly communicated, without promises?
- **Assess Logistics & Support:**
- What support is available for travel, accommodation, and on-site assistance?
- Is there clear communication in my preferred language throughout the process?
- How will follow-up be managed after the initial evaluation or procedure?
- **Personal Reflection & Goals:**
- What are my personal goals for exploring advanced treatment options?
- Am I comfortable with the experimental nature of certain advanced regenerative pathways?
- Have I discussed my considerations with trusted advisors or family members?
Using The Clarity Compass helps ensure that your journey towards exploring advanced options for ADHD is grounded in knowledge and careful consideration, not speculation.
Our Regenerative Philosophy & Approach for Neurodevelopmental Care

At Regencord in Pereira, Colombia, our approach to neurodevelopmental conditions like ADHD is rooted in a philosophy of rigorous inquiry, ethical patient advocacy, and the pursuit of innovative yet responsible pathways. We recognize the profound impact ADHD has and the urgent need for comprehensive understanding and potential solutions.
An Educational, Evidence-Informed Framework
We believe that true empowerment comes from informed choice. Our team is dedicated to educating patients and their families about the current scientific understanding of ADHD, including its neurodevelopmental aspects and the intricate role of dopaminergic regulation. When discussing advanced regenerative pathways, our focus is on clarifying what the science currently supports, what remains in research, and what potential mechanisms are being explored in controlled settings (as documented in sources like ClinicalTrials.gov and PubMed).
We do not make unverified health claims or guarantee outcomes. Instead, we present the landscape of regenerative medicine as an evolving field with promising research, allowing patients to understand the experimental nature of certain approaches and make decisions based on verifiable facts and their individual health profile.
Patient-Centric Evaluation
Our process begins with a confidential, thorough case review. This allows us to understand each patient’s unique history, current condition, and specific needs. It’s an opportunity to assess suitability for further evaluation of advanced regenerative pathways within the ethical and regulatory framework established by the Colombian Ministry of Health and INVIMA. We prioritize patient safety and well-being above all, ensuring that any considerations for advanced options are made with utmost care and transparency.
Insight 1: Patients navigating advanced care for conditions like ADHD often grapple with distinguishing between genuine scientific progress and unverified claims. Our experience underscores that clear, ethical education, precisely tailored to their individual journey, is paramount for empowering truly informed decisions.
Overcoming Common Hesitations: Why Seeking Clarity is a Strategic Advantage

It’s natural to feel a degree of hesitation when considering advanced or emerging medical pathways, especially in an international setting. Our team regularly encounters common concerns, and addressing them transparently is central to our mission.
“Is Stem Cell Treatment for ADHD Proven and Safe?”
**Addressing the Concern:** The current scientific consensus, as highlighted by authoritative bodies like the NIH and FDA, is that stem cell treatments for ADHD are largely in experimental or research phases. There are no broadly approved stem cell treatments specifically for ADHD. However, significant research continues into the potential of regenerative medicine to influence neurodevelopmental and dopaminergic regulation pathways. Our role is to guide you through this research, provide current information, and help evaluate if a specific, ethically sound, advanced regenerative pathway—which might incorporate regenerative principles—could be considered for further review based on your unique case and the latest scientific understanding. Safety is paramount, and any advanced considerations are made within regulated medical environments adhering to high standards, overseen by authorities like Colombia’s INVIMA.
“Is Receiving Medical Care in Colombia Legitimate and High Quality?”
**Addressing the Concern:** Colombia has emerged as a respected destination for medical care, known for its modern facilities, well-trained medical professionals, and robust regulatory oversight. The Colombian Ministry of Health and INVIMA ensure that medical practices and healthcare providers adhere to stringent national standards. Many facilities meet or exceed international certifications. Our team at Regencord collaborates with institutions that prioritize patient safety and high-quality care, providing a legitimate and reliable environment for exploring advanced medical options.
“The Process Sounds Too Complicated and Overwhelming. Where Do I Start?”
**Addressing the Concern:** This is a very common and understandable concern. The thought of international travel for medical purposes can feel daunting. This is precisely why our patient advocacy team exists. We are here to simplify the entire process for you. From your initial confidential case review to understanding travel logistics, accommodation options, and on-site support in Pereira, Colombia, we provide a clear, step-by-step pathway. Our goal is to transform a complex undertaking into a manageable, supported journey, allowing you to focus on your health rather than administrative burdens.
Insight 2: Beyond the clinic, the broader patient environment plays a pivotal role in recovery and well-being. Pereira, with its unique blend of advanced medical infrastructure and serene, supportive natural surroundings, offers a distinct advantage, fostering a focused and less stressful experience crucial for those exploring complex medical pathways.
“Is This Just an Expensive Alternative Without Real Benefit?”
**Addressing the Concern:** We understand the financial considerations inherent in exploring advanced medical pathways. Our initial confidential case review is designed to provide you with clarity and an honest assessment of whether an advanced regenerative pathway might be suitable for your particular situation. We focus on matching your needs with the most current scientific understanding and ethical practices, not on promoting unproven ‘cures.’ This initial step is about gaining information and understanding, allowing you to make a confident, informed decision about whether to proceed, with full transparency regarding potential costs and expected processes. Our objective is to guide you toward the most appropriate path for your health goals, ensuring that any decision is well-founded and aligned with your best interests.
Glossary of Key Terms
- **Attention Deficit Hyperactivity Disorder (ADHD):** A neurodevelopmental condition affecting attention, hyperactivity, and impulsivity.
- **Neurodevelopmental:** Relating to the development of the nervous system, especially the brain.
- **Dopaminergic Regulation:** The process by which dopamine, a neurotransmitter, is controlled in the brain; crucial for functions like attention, motivation, and reward.
- **Regenerative Medicine:** A field focused on developing methods to regrow, repair, or replace damaged or diseased cells, organs, or tissues.
- **Stem Cells:** Undifferentiated cells with the potential to develop into many different cell types, and to self-renew.
- **Preclinical Studies:** Research conducted before clinical trials, often involving laboratory experiments and animal models.
- **Clinical Trials:** Research studies conducted with human volunteers to assess the safety and potential effectiveness of new treatments or interventions.
- **INVIMA (Instituto Nacional de Vigilancia de Medicamentos y Alimentos):** Colombia’s national regulatory agency responsible for the surveillance and control of medicines, food, medical devices, and other health-related products.
- **Patient Advocacy:** Support and guidance provided to patients to help them navigate the healthcare system, understand their options, and make informed decisions.
Frequently Asked Questions (FAQs)
Here are answers to some common questions patients have when considering advanced pathways for ADHD:
- Is stem cell treatment for ADHD a proven therapy?
- Currently, stem cell treatments for ADHD are largely in experimental or research phases. Reputable scientific bodies like the National Institutes of Health (NIH) emphasize that while research into neurodevelopmental disorders and regenerative medicine holds promise, these approaches are not yet considered standard, approved treatments for ADHD. Our approach at Regencord focuses on understanding the current scientific landscape and evaluating whether advanced regenerative pathways are suitable for an individual patient based on the latest research and ethical considerations.
- How does Regencord in Pereira, Colombia, approach ADHD and regenerative medicine?
- The team at Regencord in Pereira, Colombia, emphasizes an educational and patient-centric approach. We focus on providing comprehensive information about neurodevelopmental conditions like ADHD and exploring potential advanced regenerative pathways within a regulated, ethical framework. This involves a thorough case review to understand a patient’s unique profile, discuss the scientific basis of various options, and determine if any emerging regenerative strategies might be appropriate for further evaluation.
- What are the safety considerations for exploring advanced medical treatments in Colombia?
- Colombia has a well-developed healthcare system with strong regulatory bodies, including the Ministry of Health and INVIMA (National Food and Drug Surveillance Institute), which oversee medical practices and product safety. Institutions affiliated with Regencord adhere to high national and international standards. Our team assists patients in understanding these regulations and ensuring that any advanced pathways considered are offered within a framework of patient safety and ethical practice.
- What are the logistical aspects of seeking care in Pereira, Colombia?
- Considering advanced care internationally can seem complex, but our patient advocacy team is dedicated to simplifying the process. We assist with initial case reviews, information on travel logistics, accommodation suggestions, and on-site support. Our goal is to make the journey to Pereira as seamless and stress-free as possible, allowing you to focus on your health and evaluation process. We provide clarity on each step, from your initial inquiry to your return home.
- What is the next step if I am interested in learning more?
- The most important next step is to obtain a confidential case review. This allows our team to understand your unique medical history and discuss potential pathways tailored to your situation, providing you with the clarity and information needed to make informed decisions.
Discover if you are a candidate for the regenerative medicine pathways available through the team at Regencord in Pereira, Colombia. Contact us for a confidential case review.
Disclaimer: The information provided in this article is for educational purposes only and is not intended as medical advice. It should not be used to diagnose or treat a health problem or disease. Always consult with a qualified healthcare provider for any health concerns or before making any decisions related to your health or treatment. Outcomes are not guaranteed. Veris Salus LLC serves as a marketing and patient-coordination facilitator for services provided by the Regencord team in Pereira, Colombia. All clinical decisions and treatments are solely the responsibility of the treating medical professionals at Regencord.



